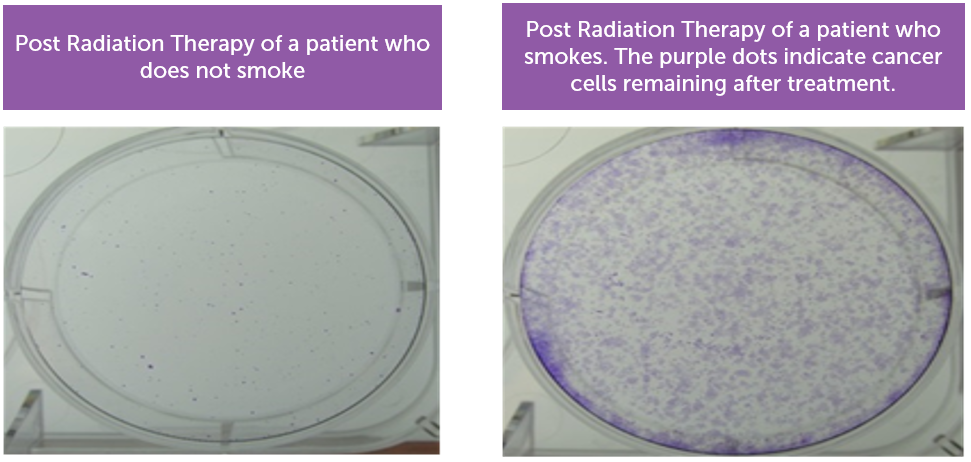

There are many benefits to quitting tobacco use, especially if you are going to have surgery or cancer treatment.
Quitting tobacco can be hard.
Maybe you’ve already tried. That’s pretty normal. Nicotine, one of the main chemicals in tobacco, is highly addictive. It usually takes several attempts to quit smoking.
Remind yourself of all the things you can gain during this journey:
- Within 20 minutes: Your heart rate and blood pressure drop.
- Within 12 hours: The oxygen levels in your blood return to normal.
- Within 48 hours: Your sense of taste and smell begin to improve.
- Within 2-3 weeks: Exercising becomes easier and your lung capacity can increase by 30%
- Within 1-9 months: You’ll have more energy, cough less and breathe better.
- Within 10 years: Your risk of getting lung cancer and dying from it is roughly cut in half compared to someone who is still smoking.
People who smoke are at greater risk of surgical complications than people who do not smoke. It takes longer surgical wounds to heal and a higher chance of wound infection.
Evidence shows that when you quit smoking at least four weeks before surgery:
- You will have better breathing, blood pressure and heart rate
- You will have less risk of problems during and after surgery
- You will have less risk of getting lung, chest and wound infections
- Your wounds will heal faster
- You may get to go home sooner
Stop Smoking Before Surgery Fact Sheets in
English,
French,
Traditional Chinese,
Simplified Chinese,
Punjabi,
Tagalog,
Korean,
Persian,
Spanish,
Vietnamese, and
German.
Even after a cancer diagnosis, it’s never too late to stop smoking. Quitting tobacco use before treatment can improve survival by up to 30 per cent. This applies to all cancer treatments including radiation therapy, chemotherapy and surgery.
- Radiation therapy works better if the level of oxygen in your body is normal. When you smoke, the level of oxygen in your blood drops, making it harder for radiation to do its job.
- Chemicals in cigarette smoke lower the amount of chemotherapy drugs in your blood, meaning chemotherapy cannot work as well.
The BC Cancer Smoking Cessation Program aims to help all new BC Cancer patients to stop smoking. Patients in all cancer centres are asked about their current smoking and offered advice on the benefits of quitting then referred to the provincial quit line—QuitNow.
For more information, visit the program page.
For people who don’t smoke, breathing in second-hand smoke can cause serious health problems. Even brief exposures can be harmful.
Reduce the health risks of second-hand smoke by making your home and car smoke-free:
- Have a no-smoking rule in your home. If you smoke, take it outside and away from doors and windows. Ask guests to do the same.
- Have a no-smoking rule in your car, even when the windows are down. Remind passengers not to smoke in your car.
- Clean your clothes, carpet, drapes, bedding, furniture and walls to remove the smell of smoke. Don't forget to clean the inside of your car, too!
- Teach your children to stay away from second-hand smoke.
In B.C, there are many free, helpful resources to help you on your journey to stop smoking and using tobacco products:
- BC Smoking Cessation Program: offers free nicotine replacement therapy (e.g., nicotine gum or patches) and covers some quit smoking prescription medications to BC residents with active Medical Services Plan coverage and those eligible for Fair Pharmacare.
- QuitNow: provides free counselling online, by phone (1-877-455-2233) or by text QUITNOW to 654321.
- Talk Tobacco: provides free, culturally-appropriate and confidential support for quitting or reducing smoking or vaping for First Nations, Inuit and Métis people. Connect with a Quit Coach by phone (1-833-998-8255), text message or live chat.
- Respecting Tobacco (First Nations Health Authority): Free resources and information about sacred tobacco, including videos and podcasts.
- Call 8-1-1 for 24/7 health information and advice to help you quit.
- Ask your loved ones, friends or a health care provider to help you make a plan that works for you.